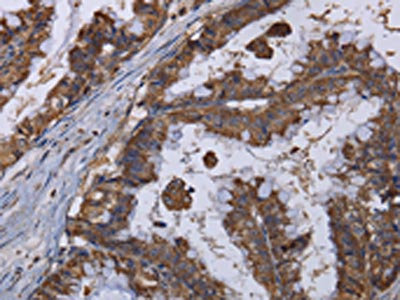

MT3 Antibody
-
中文名稱:MT3兔多克隆抗體
-
貨號:CSB-PA789465
-
規格:¥1100
-
圖片:
-
其他:
產品詳情
-
Uniprot No.:
-
基因名:MT3
-
別名:GIF antibody; GIFB antibody; GRIF antibody; Growth inhibitory factor antibody; Metallothionein 3 (growth inhibitory factor (neurotrophic)) antibody; Metallothionein 3 antibody; Metallothionein III antibody; Metallothionein-3 antibody; Metallothionein-III antibody; Mt 3 antibody; MT III antibody; MT-3 antibody; MT-III antibody; MT3 antibody; MT3_HUMAN antibody; ZnMT3 antibody
-
宿主:Rabbit
-
反應種屬:Human,Mouse,Rat
-
免疫原:Fusion protein of Human MT3
-
免疫原種屬:Homo sapiens (Human)
-
標記方式:Non-conjugated
-
抗體亞型:IgG
-
純化方式:Antigen affinity purification
-
濃度:It differs from different batches. Please contact us to confirm it.
-
保存緩沖液:-20°C, pH7.4 PBS, 0.05% NaN3, 40% Glycerol
-
產品提供形式:Liquid
-
應用范圍:ELISA,IHC
-
推薦稀釋比:
Application Recommended Dilution ELISA 1:2000-1:5000 IHC 1:50-1:200 -
Protocols:
-
儲存條件:Upon receipt, store at -20°C or -80°C. Avoid repeated freeze.
-
貨期:Basically, we can dispatch the products out in 1-3 working days after receiving your orders. Delivery time maybe differs from different purchasing way or location, please kindly consult your local distributors for specific delivery time.
-
用途:For Research Use Only. Not for use in diagnostic or therapeutic procedures.
相關產品
靶點詳情
-
功能:Binds heavy metals. Contains three zinc and three copper atoms per polypeptide chain and only a negligible amount of cadmium. Inhibits survival and neurite formation of cortical neurons in vitro.
-
基因功能參考文獻:
- This study suggest that MT3 gene polymorphisms are not associated with autism. PMID: 29524106
- In recent years, the roles of zinc dynamics and MT3 function in neurodegeneration are slowly emerging. This short review focuses on the recent developments regarding the chemistry and biology of MT3. [review] PMID: 28538697
- C-terminal domain of MT3 confers dome formation in MCF-7 cells and the presence of this domain induces expression of the GAGE family of genes. The differential effects of MT3 and metallothionein 1E on the expression of GAGE genes suggests unique roles of these genes in the development and progression of breast cancer. PMID: 28545470
- The expression of MT-3 mRNA in breast cancer cell lines was significantly lower than in the normal human breast epithelial cell line. The results suggest that MT-3 may play a role in the malignant transformation of breast epithelial cells and in tumor progression. PMID: 27840910
- The epidermis of human skin and resulting malignancies express high level of MT-3. PMID: 25290577
- The study implicates the unique C-terminal sequence of MT-3 in the conversion of HK-2 cells to display an enhanced epithelial phenotype. PMID: 25803827
- MT3 may regulate breast cancer cell invasiveness by modulating the expression of MMP3. PMID: 25933064
- The presence of MT-3 in the zona glomerulosa of pathological adrenal cortex may imply a role in the pathophysiology of aldosterone-producing tissues. PMID: 24242700
- MT-capital I, Ukrainiancapital I, Ukrainiancapital I, Ukrainian increases the amount of active ADAM10 in association with furin, PC7 and PKCalpha. PMID: 24859040
- Upregulation of MT-3 gene expression can inhibit esophageal cancer cell proliferation and induce apoptosis. PMID: 24222235
- The experiments indicate that MT3 is an androgen-upregulated gene, and promotes tumorigenesis of prostate carcinoma cells. PMID: 23794209
- the molecular mechanism for protection against the neuronal cytotoxicity of Abeta(1-42) with copper ions PMID: 23086305
- MT-III expression may have an impact on the pathogenesis of non-small cell lung cancer. PMID: 23482768
- MT-3 modulates the catalytic redox properties of PrP-Cu(II) PMID: 22615124
- Esophageal adenocarcinomas are characterized by frequent epigenetic silencing of MT3. PMID: 21818286
- Metallothionein-III is a specific component of glial cytoplasmic inclusions and is upregulated in multiple system atrophy. PMID: 20039155
- The roles of zinc and metallothionein-3 in autophagy and/or lysosomal function are reviewed. PMID: 20974010
- MT-3 expression is involved in the transport function of a human renal cell line that retains properties of the proximal tubule. PMID: 11849386
- Overexpression of human metallothionein-III prevents hydrogen peroxide-induced oxidative stress in human fibroblasts. "metallothionein-III " PMID: 12067712
- overexpression can influence the growth and chemotherapeutic drug resistance of the PC-3 prostate cancer cell line PMID: 12111700
- Hypermethylation of metallothionein-3 CpG island in gastric carcinoma PMID: 12538345
- Metallothionein-III has anticarcinogenic and neuroprotective roles in cells exposed to gamma rays PMID: 15190073
- The affect the role of MT3 on cell viability, which may explain in part why the comprehensive effect of MT3 on the cells was elusive. PMID: 16087360
- analysis of the epitope of neuronal growth inhibitory factor (GIF) PMID: 16336778
- MT3 expression is frequently down-regulated in oesophageal squamous cell carcinoma , by DNA methylation, but that this is not a prognostic indicator PMID: 16351731
- mutation of MT3 at Glu23 may alter the NO metabolism and/or affect zinc homeostasis in brain, thus altering the neuronal growth inhibitory activity PMID: 16945328
- The alpha-domain is indispensable and plays an important role in modulating the stability of the metal cluster in the beta-domain by domain-domain interactions, thus influencing the bioactivity of hMT3. PMID: 17712581
- The level of MT-3 expression in human proximal tubular cells influences transepithelial resistance and cadherin expression but does not the Cd(+2)-induced loss of vectorial active transport. PMID: 18182399
- MT-3 is a highly hypoxia-inducible gene in human adipocytes; the protein may protect adipocytes from hypoxic damage PMID: 18206644
- These results suggest that MT-III upregulates VEGF production in brain endothelial cells by a HIF-1alpha-dependent mechanism. PMID: 18295594
- The structure adopted by the (6)CPCP(9) motif is the determinant factor of the inhibitory bioactivity of hGIF; but residues within the N-terminal fragment may also influence the peptide conformation and contribute to the protein's bioactivity. PMID: 18533104
- Metallothionein-III-induced activation of phosphatidylinositol 3-kinase/Akt and extracellular signal-regulated kinase1/2 up-regulates expression and activity of heme oxygenase-1, which provides protection against oxidative damage in dopaminergic cells. PMID: 18554677
- the bioactivity of hGIF is mainly related to the essential metal release and its characteristic conformation. PMID: 18757100
- metallothionein in decidual cells seems to be responsible for the proper coexistence between decidual cells and activated immune cells that infiltrate both eutopic and ectopic decidua during cesarean section and placental abruption PMID: 18782281
- In this study, the binding of Zn(2+), Ca(2+), and Mg(2+) to human Zn(7)MT-3 and its mutant lacking an acidic hexapeptide insert, Zn(7)MT-3(Delta55-60), was investigated and compared with the binding of Zn(7)MT-2. PMID: 19425569
- Results provide information on the domain-domain interaction at the molecular level, and shed new light on the mechanism of the bioactivity of human neuronal growth inhibitory factor. PMID: 19490120
- study of reaction/binding of cisplatin and transplatin with MT-3 and MT-2 initially bound with zinc; study includes kinetics and stoichiometry of the reactions PMID: 19536566
- weak in pancreatic serous cystadenomas; increased expressions in adenomocarcinomas; potential prognostic marker PMID: 19578815
顯示更多
收起更多
-
蛋白家族:Metallothionein superfamily, Type 1 family
-
組織特異性:Abundant in a subset of astrocytes in the normal human brain, but greatly reduced in the Alzheimer disease (AD) brain.
-
數據庫鏈接:
Most popular with customers
-
-
Phospho-YAP1 (S127) Recombinant Monoclonal Antibody
Applications: ELISA, WB, IHC
Species Reactivity: Human
-
-
-
-
-
-